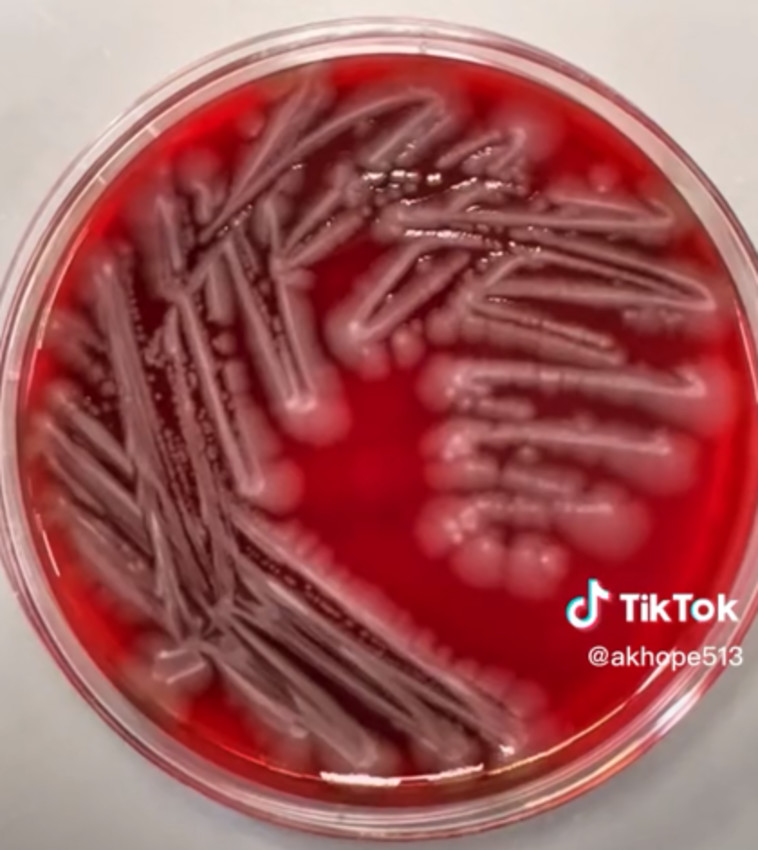
חיידקי אי-קולי בתוך אגר דם אחרי הדגרה של 24 שעות, מחריד

בקליפ נוסף שצבר תשע מיליון צפיות, החוקרת בדקה את כמות החיידקים שמסתתרים על מושב אסלה ציבורי ומצאה כי הוא מכיל גידול של חיידקי אי-קולי. "אין סיבה להיכנס לפאניקה, אלא אם יש לכם פצע פתוח כלשהו", הבטיחה לעוקביה. בסרטון אחר, בדקה את מסך מכשיר הנייד שלה, וגילתה כי הוא מכיל יותר חיידקים ממה שחשבה בתחילה.

"הגיע הזמן שנתחיל לנקות את הנייד שלנו", הודתה אמאני. אמנם, לא כל מכשיר נייד מכיל חיידקי סטפילוקוקוס, אך היא הסבירה שעדיף לנקות את הסמארטפון מאשר לקחת סיכון. "נגבו את הטלפון שלכם עם מגבון חיטוי. אתם נוגעים בו כל היום ומעבירים חיידקים אליו וממנו - לכל דבר בכל מקום", היא חידדה.
המדענית הסבירה לעוקביה כי למרות שהסרטונים שהיא מפרסמת יכולים להיות מדאיגים במיוחד, היא טענה כי אין כל סיבה להיכנס להיסטריה, אך מומלץ לקדם את החשיבות של ניקיון כללי והיגיינה.

